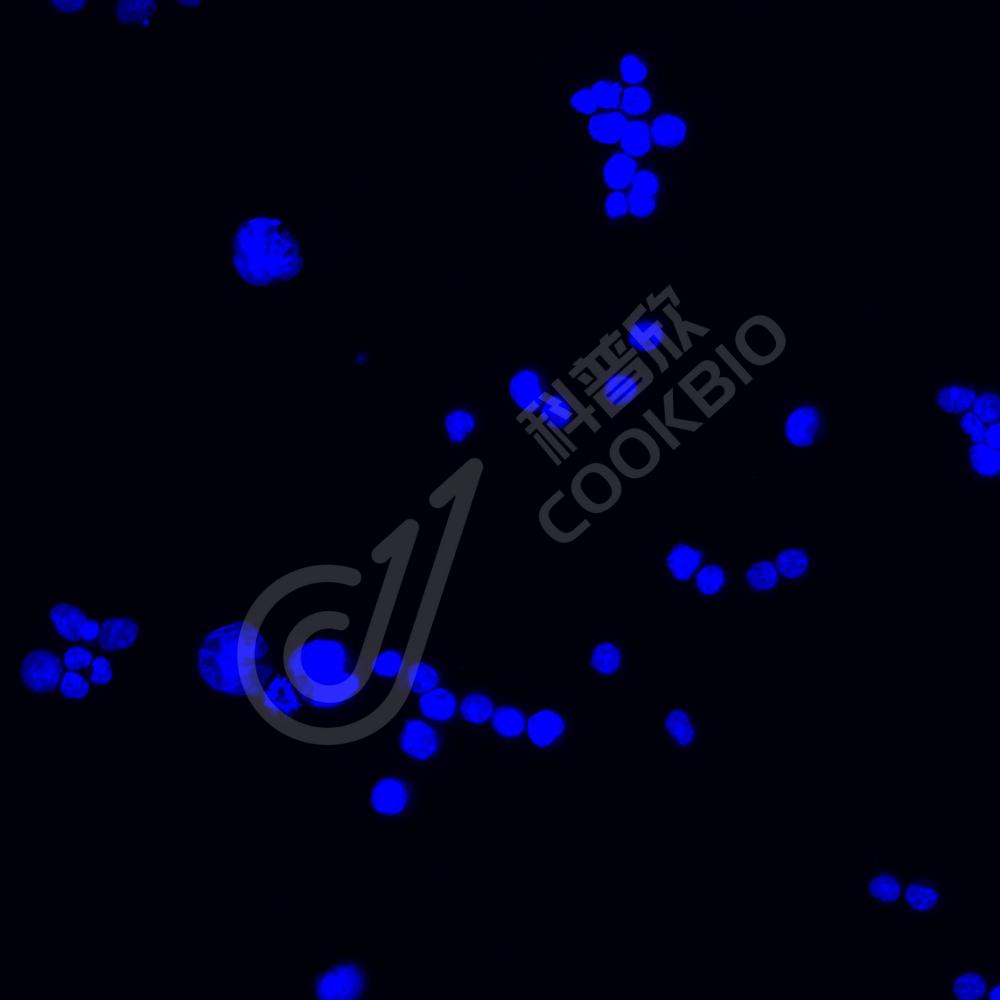
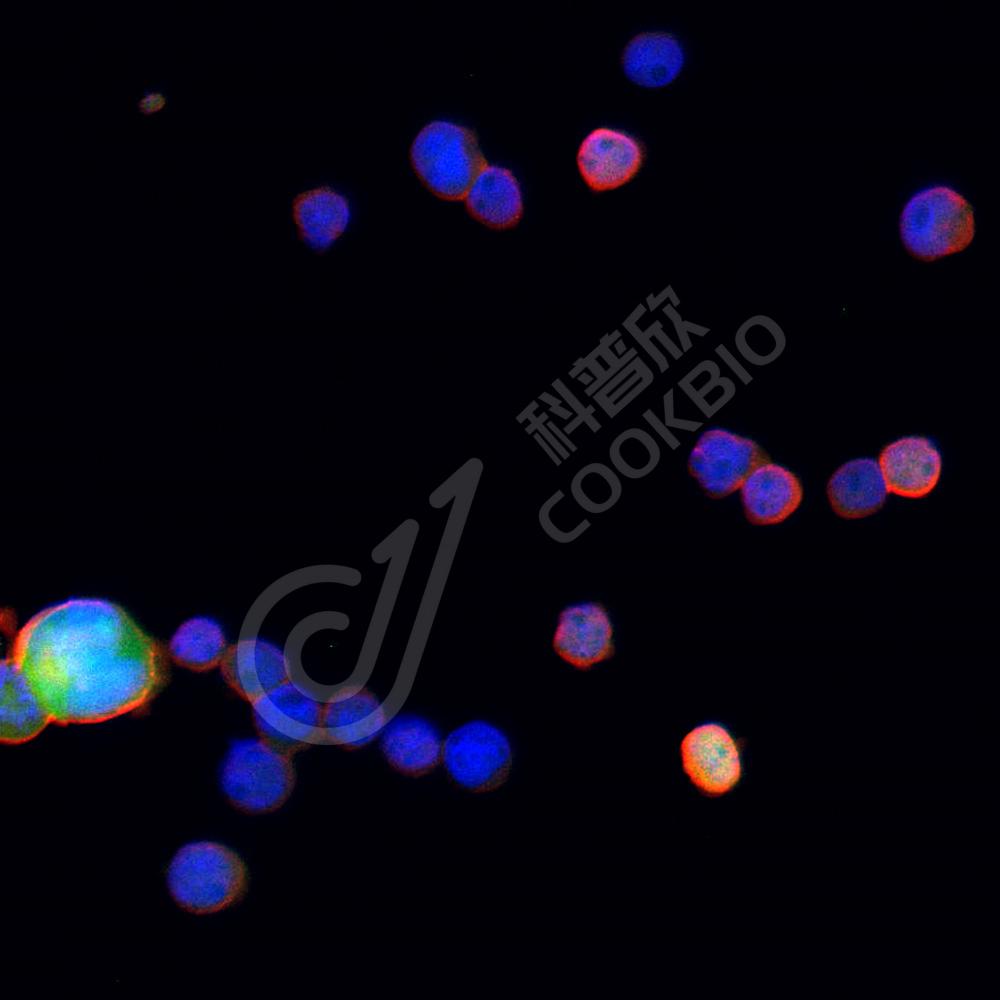

抗体筛选:
抗体筛选:
-
Recombinant Anti-MYC Tag antibody (兔单克隆抗体) 兔单抗 重组重组抗体,标签抗体货号:K5450063-100 规格:100 μL ¥ 980比较查看详情
-
Recombinant Anti-MBP Tag antibody (兔单克隆抗体) 兔单抗 重组重组抗体,标签抗体货号:K5450129-100 规格:100 μL ¥ 980比较查看详情
-
Recombinant Anti-S Tag antibody (兔单克隆抗体) 兔单抗 重组重组抗体,标签抗体货号:K5450207-100 规格:100 μL ¥ 980比较查看详情
-
Recombinant Anti-V5 tag antibody (兔单克隆抗体) 兔单抗 重组重组抗体,标签抗体货号:K5450216-100 规格:100 μL ¥ 980比较查看详情
-
Recombinant Anti-V5 tag antibody (小鼠单克隆抗体) 鼠单抗 重组重组抗体,标签抗体货号:K545057-100 规格:100 μL ¥ 980比较查看详情
-
Recombinant Anti-HA Tag antibody (小鼠单克隆抗体) 鼠单抗 重组重组抗体,标签抗体货号:K5453756-100 规格:100 μL ¥ 980比较查看详情
-
Recombinant Anti-EGFP antibody (兔单克隆抗体) 兔单抗 重组重组抗体,标签抗体货号:K546809-100 规格:100 μL ¥ 980比较查看详情
需要技术支持?
如果您有任何问题或如果您在实验过程中遇到问题,或需要更详细的技术指导,请联系我们的技术支持团队
 400-6027-270
400-6027-270
联系我们
如果您对我们的公司或产品有任何疑问,欢迎随时联系我们

湖北省武汉市东湖新技术开发区高新二路388号生物医药加速器22栋5楼
湖北省武汉市东湖新技术开发区高新二路388号生物医药加速器22栋5楼  400-6027-270
400-6027-270  鄂公网安备42018502008544号
鄂公网安备42018502008544号